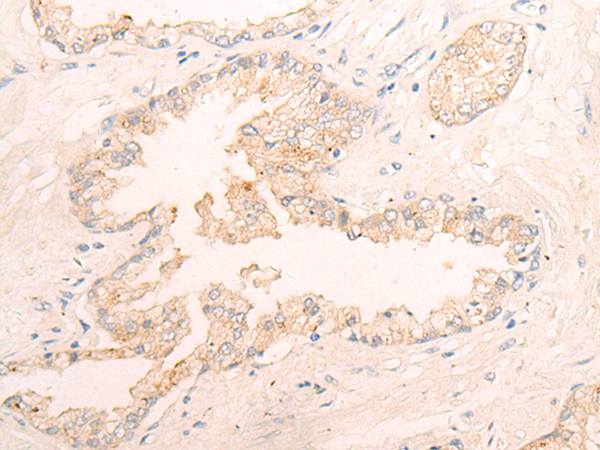

|
Background: |
Elastases form a subfamily of serine proteases that hydrolyze many proteins in addition to elastin. Humans have six elastase genes which encode structurally similar proteins. The encoded preproprotein is proteolytically processed to generate the active protease. Following activation, this protease hydrolyzes proteins within specialized neutrophil lysosomes, called azurophil granules, as well as proteins of the extracellular matrix. The enzyme may play a role in degenerative and inflammatory diseases through proteolysis of collagen-IV and elastin. This protein also degrades the outer membrane protein A (OmpA) of E. coli as well as the virulence factors of such bacteria as Shigella, Salmonella and Yersinia. Mutations in this gene are associated with cyclic neutropenia and severe congenital neutropenia (SCN). This gene is present in a gene cluster on chromosome 19. |
|
Applications: |
ELISA, IHC |
|
Name of antibody: |
ELANE |
|
Immunogen: |
Synthetic peptide of human ELANE |
|
Full name: |
elastase, neutrophil expressed |
|
Synonyms: |
GE; NE; HLE; HNE; ELA2; SCN1; PMN-E |
|
SwissProt: |
P08246 |
|
ELISA Recommended dilution: |
5000-10000 |
|
IHC positive control: |
Human thyroid cancer and Human prostate cancer |
|
IHC Recommend dilution: |
30-150 |
購物車
幫助
021-54845833/15800441009
